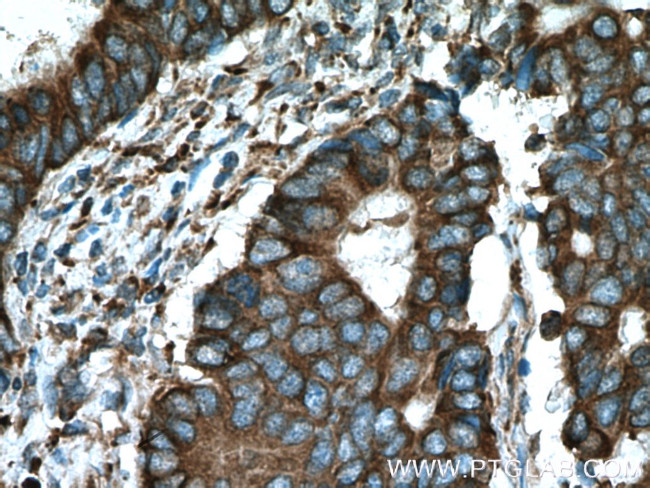
C8orf48 Antibody in Immunohistochemistry (Paraffin) (IHC (P))
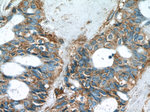
C8orf48 Antibody in Immunohistochemistry (Paraffin) (IHC (P))
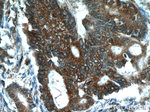
C8orf48 Antibody in Immunohistochemistry (Paraffin) (IHC (P))
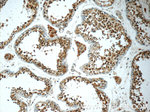
C8orf48 Antibody in Immunohistochemistry (Paraffin) (IHC (P))

Search
Proteintech
C8orf48 Polyclonal Antibody
{{$productOrderCtrl.translations['antibody.pdp.commerceCard.promotion.promotions']}}
{{$productOrderCtrl.translations['antibody.pdp.commerceCard.promotion.viewpromo']}}
{{$productOrderCtrl.translations['antibody.pdp.commerceCard.promotion.promocode']}}: {{promo.promoCode}} {{promo.promoTitle}} {{promo.promoDescription}}. {{$productOrderCtrl.translations['antibody.pdp.commerceCard.promotion.learnmore']}}
产品信息
25020-1-AP
种属反应
宿主/亚型
分类
类型
抗原
偶联物
形式
浓度
纯化类型
保存液
内含物
保存条件
运输条件
产品详细信息
Immunogen sequence: MAICPELAQ TDKSALANLS DETETLKNFT DEVQTSSSFS SSGGRQSSPL TSGSKLEREK QTPSLEQGDT QSELLDYKNY EKKLSKKWIN YLKLKDSNFE RHQPDTKLPT EITRVSDEEL NALQSYCTMK INLIHRRGDS KKKTSSRHKK LHLGLDVEAS ERDAFSCTVP DELLNRIYFK NMRTTPKQEA AAKQHISYQC PYCNRKRAEL ALSAFLKQKK TLLESFLLQE RIDEHLHTKD FLTRIGEAHQ DFPRLSDDPR IIWKRLTEKS HIRYSGFERS ETEQKMQRDG NSACHLPFSL PFLKRLTLIK PELVIVNDNV (1-319 aa encoded by BC031245)
靶标信息
The C8orf48 gene has been identified as a critical biomarker in colorectal cancer (CRC). Research indicates that C8orf48 plays a significant role in inhibiting tumorigenesis by regulating key signaling pathways. This gene is negatively associated with KRAS, BRAF, and MAP2K2 in normal colorectal tissues and negatively correlated with MAP2K2 in CRC tissues. These associations suggest that C8orf48 may function as a tumor suppressor by modulating pathways involved in cell proliferation, migration, and invasion. The gene's expression and methylation profiles have been extensively studied using data from The Cancer Genome Atlas (TCGA), and functional assays have confirmed its inhibitory effects on CRC cell growth. Additionally, C8orf48 has been identified as a direct target of miR-556, further elucidating its regulatory mechanisms. The findings underscore the potential of C8orf48 as a novel target for CRC prediction and therapy.
仅用于科研。不用于诊断过程。未经明确授权不得转售。
篇参考文献 (0)
生物信息学
蛋白别名: Uncharacterized protein C8orf48
基因别名: C8orf48
UniProt ID: (Human) Q96LL4
Entrez Gene ID: (Human) 157773